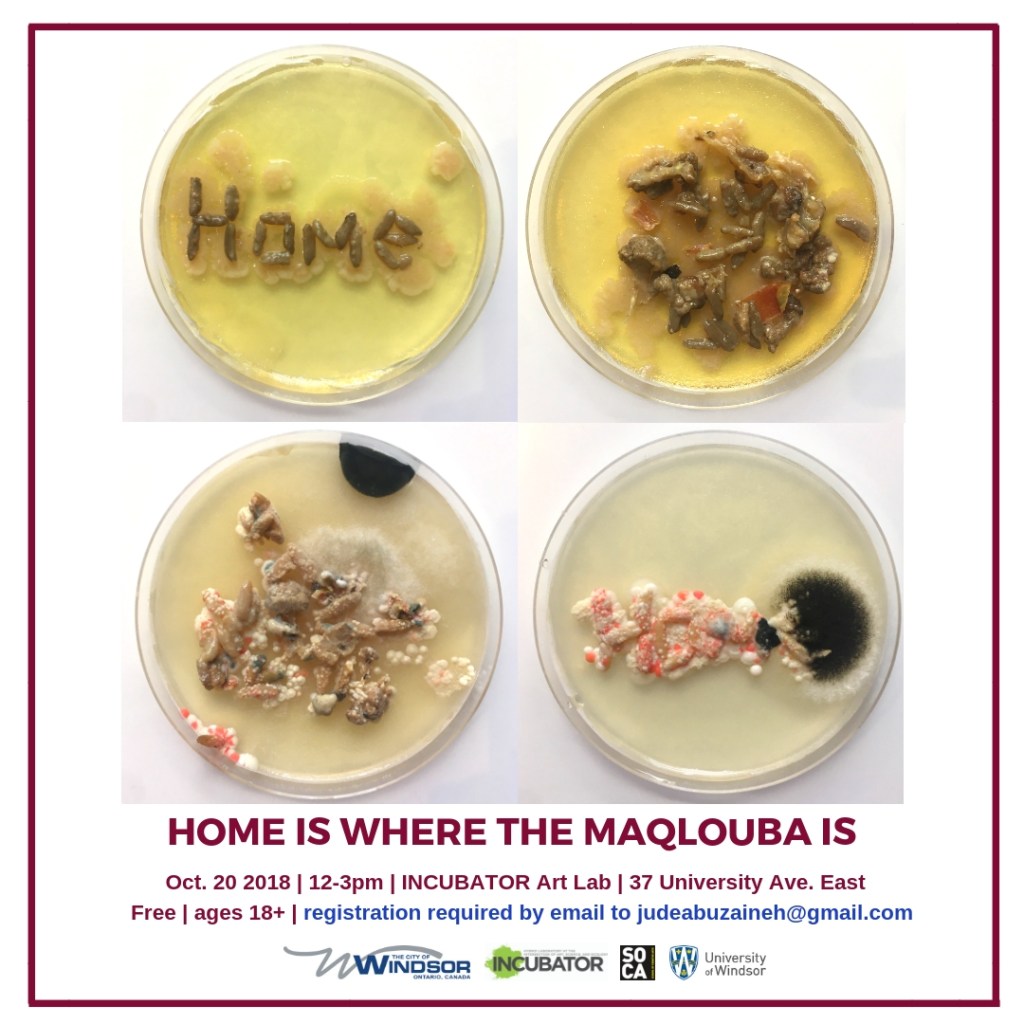

Due to the current coronavirus disease (COVID-19) worldwide situation this event has been cancelled.
The March 20th-21st daytime FEMeeting sessions will be private. On Saturday evening there will be a public community potluck dinner and talks by the renowned artists Marta de Menezes (Portugal) and Kira O’Reilly (Ireland/Finland), open to all.
Schedule
6:00 p.m. | Community potluck dinner
7:00 p.m. | Artist Talks and Community Conversation with Marta de Menezes (Portugal) and Kira O’Reilly (Ireland/Finland)
More info: https://www.mediasanctuary.org/event/femeeting-troy-artist-talks-and-community-meal/
Featured Artists

Kira O’Reilly is a London based artist; her practice, both willfully interdisciplinary and entirely undisciplined, stems from a visual art background; it employs performance, biotechnical practices and writing with which to consider speculative reconfigurations around The Body. But she is no longer sure if she even does that anymore. Since graduating from the University of Wales Institute Cardiff in 1998 her work has been exhibited widely throughout the UK, Europe, Australia, China and Mexico. She has presented at conferences and symposia on both live art and science, art and technology interfaces. She has been a visiting lecturer in the UK and Australia and U.S.A in visual art, drama and dance. Most recent new works have seen her practice develop across several contexts from art, science and technology to performance, live art and movement work

Marta de Menezes is a Portuguese artist with a degree in Fine Arts by the University in Lisbon, a MSt in History of Art and Visual Culture by the University of Oxford, and a PhD candidate at the University of Leiden.She has been exploring the intersection between Art and Biology, working in research laboratories demonstrating that new biological technologies can be used as new art medium. In 1999 de Menezes created her first biological artwork (Nature?) by modifying the wing patterns of live butterflies. Since then, she has used diverse biological techniques including functional MRI of the brain to create portraits where the mind can be visualised (Functional Portraits, 2002); fluorescent DNA probes to create micro-sculptures in human cell nuclei (nucleArt, 2002); sculptures made of proteins (Proteic Portrait, 2002-2007), DNA (Innercloud, 2003; The Family, 2004) or incorporating live neurons (Tree of Knowledge, 2005) or bacteria (Decon, 2007). Her work has been presented internationally in exhibitions, articles and lectures. She is currently the artistic director of Ectopia, an experimental art laboratory in Lisbon, and Director of Cultivamos Cultura in the South of Portugal. http://martademenezes.com
Speakers

Katherine Behar, “Gurgles, Guesses, and Ghosts in the Machine: Art and ‘Artificial Ignorance’”
Baruch College and The Graduate Center, City University of New York

Hazelle Lerum, “For Novelty Use Only”
Rensselaer Polytechnic Institute

Anna Lindemann, “THE COLONY”
Digital Media & Design Department, University of Connecticut

Boryana Rossa, “Is our spirituality genetically predisposed?”
Sofia Queer Forum & UTRAFUTURO

Jenifer Wightman, “Chestertown Universe”
Cornell University

Suzanne Thorpe, “TECHNE”
TECHNE

Jennifer Zackin, “Vortex Weavings”
Independent Artist

Ryder Cooley, “Re-Framing Parasitism”
Rensselaer Polytechnic Institute and Rhode Island School of Design

Hana van der Kolk, “Grief Points”
Rensselaer Polytechnic Institute
Jude Abu Zaineh, “Home is where the Maqlouba is”
Rensselaer Polytechnic Institute

Stephanie Rothenberg, “Aphrodisiac in the Machine”
Department of Art, SUNY Buffalo

Claudia Jacques, “Water and Light: Ode to a River”
Independent Artist

Stephanie Loveless, “Vocal Becoming”
Rensselaer Polytechnic Institute

Hined Rafeh, “Hands, touching hands; Genes, touching genes”
Rensselaer Polytechnic Institute

Nancy D. Campbell, “Relational Autonomy: Towards a Feminist Ethicopolitics of Harm Reduction”
Rensselaer Polytechnic Institute

Allison Berkoy, “ARE YOU PREPARED?”
New York City College of Technology, CUNY

Tamar Gordon, “Contemporary Euro-American spiritualist practice”
Rensselaer Polytechnic Institute

Angela Beallor, “MG (aka I Want a Baby! Reimagined)”
Rensselaer Polytechnic Institute

Elizabeth Press, “The labor of breastfeeding and breastmilk pumping”
Rensselaer Polytechnic Institute

Ellie Irons, “Invasive Surfaces of the Americas: Kudzu, Asphalt, and Turfgrass”
Rensselaer Polytechnic Institute

Kathleen McDermott, “Urban Armor”
Rensselaer Polytechnic Institute

Carolyn Angleton, “What is considered an artistic practice”
ARC-BAC

Joan Linder, “Remedy, 2018”
Department of Art, University at Buffalo SUNY
